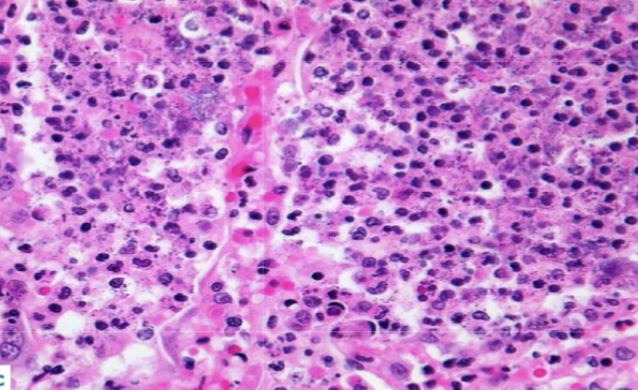
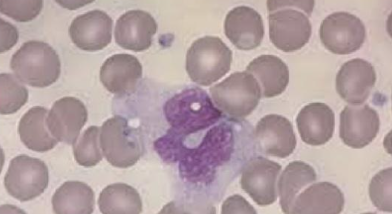
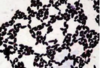

Chronic inflammation in asthma
IgE mediated

Airways infiltrated with mast cells (A) and CD4 T lymphocytes (B)
Chronic asthma

Creola bodies → found in sputum, ciliated columnar cells from bronchial mucosa
Asthma

Charcot-Leyden crystals → lysophospholipase, liberated from eosinophil breakdown
Asthma

Asthma - mucus plugging, eosinophilic infiltration, thickened basement membrane, epithelial denudation, goblet cell hyperplasia
Air spaces filled with fluid and inflammatory infiltrate – lobar pneumonia

BAL: acute inflammatory cells
Probably VIRAL - lymphocyte

lymphoid follicles and germinal centres in the lung! Usual interstitial pneumonia (UIP) pattern

Gross pathology – fibrotic changes in lower lobes, elastic hard consistency, diffuse destruction of lung mesenchyme, multiple air cysts with honeycomb change
Usual interstitial pneumonia (UIP) pattern

Microscopically, dense fibrosis and destruction of alveolar architecture.
Active fibrotic lesions composed of myofibroblasts
Aggregation of spindle cells with gray to pale purple matrix adjacent to dense fibrosis
Usual interstitial pneumonia (UIP) pattern

An asbestos body

Emphysema

Streptococcus pneumoniae
Gram positive diplococci
Can aid identification through use of capsule stain

Aspergillus in Lungs

Klebsiella pneumoniae
Gram negative bacilli

Granuloma
Peripheral blood monocyte

Granuloma = aggregate of ‘epithelioid’ histiocytes

Lung TB

Sarcoid granuloma

TB – caseating granuloma with central necrosis.

TB – caseating granuloma with central necrosis.

Ziehl-Neelson (ZN) stain → shows acid fast bacilli

Grocott stain shows fungi